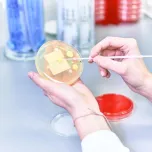
Non-sterile Product Testing

Non-sterile Product Testing
Products

Information
Non-sterile products
In the area of non-sterile products, the Labor LS tests pharmaceuticals, medical devices, single-use devices, cosmetics and waters/production waters and various intermediate products as part of in-process controls. Depending on the product and category, non-sterile products must meet certain minimum requirements for microbiological purity in order to be marketable. Furthermore, specified microorganisms must not be present in the products and must be microbiologically stable. To this purpose, current pharmacopoeias and standards define specifications for product groups in which the total permissible burden with reproductive microorganisms is defined. In addition to our extensive expertise in professional routine testing, our customers also benefit from our wealth of experience in the validation of these methods.
- Bioburden determination
- Total microbial count determination
- Identification of Microorganism
- Qualification Service Cleanrooms and Utilities
